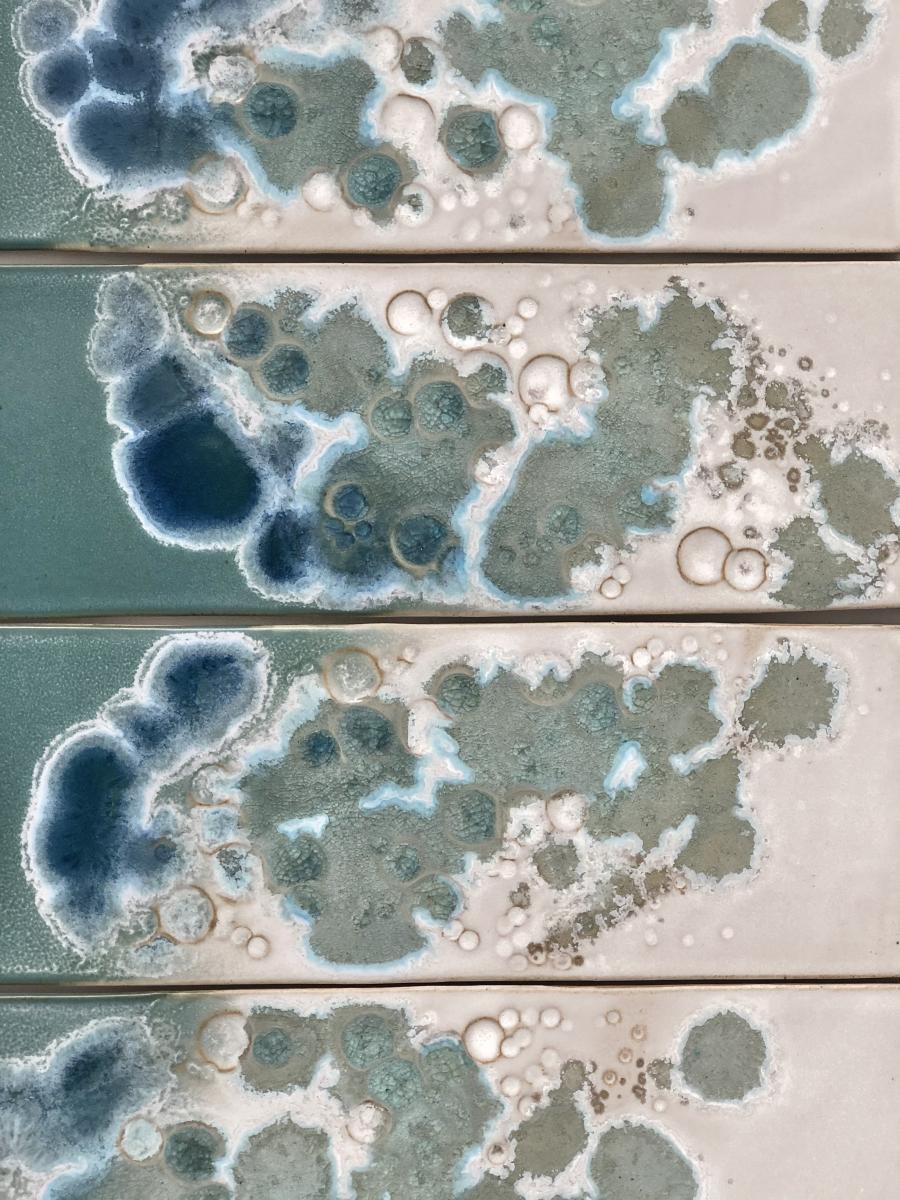
Coastal Panel Collection (5 piece set) picture

Martin Pottery
Martin Pottery
 Coastal Panel Collection (5 piece set)
Coastal Panel Collection (5 piece set)
Description
This 5 piece panel collection is inspired by the beautiful coastlines. With teals and aquas combined with a soft whitewash. The texture and wave of stunning glass flow over the collection creating movement. This set comes with wall hangers to make ease for hanging. Each panel approximately 21 inches x 6 inches
Item details
Price
$1,250.00
Quantity available
2
Shipping
Free
Refund & return policy
No refund or returns allowed on this purchase.
Exceptions may apply. Please message Jenny for more information.
Meet your seller
Check out other items by Martin Pottery
Coastal Panel Collection (5 piece set)
Martin Pottery
Heads up! This seller has been inactive since 02-12-2021.We suggest messaging the seller to check item availability before purchasing.